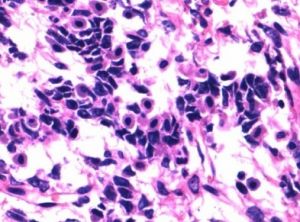
卵巢兩性母細胞瘤

發病原因
該病病因尚未明確。臨床症狀
一、症狀1、盆腔包塊:多發生於單側,平均直徑6cm以下。通過盆腔
卵巢兩性母細胞瘤
卵巢兩性母細胞瘤2、內分泌變化,瘤細胞分泌雌激素及雄激素,可有單種症狀,亦有男、女性症狀均存在或先後出現症狀者。
(1)雌激素影響:
A.出現月經過多、絕經後出血等
B.出現子宮增大、子宮內膜增生性病理改變。
(2)雄激素影響:
出現男性化症狀:閉經、乳腺萎縮、多毛、聲音低啞、陰蒂肥大等。
臨床診斷
腫瘤組織內必須同時含有支持間質細胞成分和顆粒-泡膜細胞成分血清中出現抑制素(inhibin)及MIC2抗體的:存在型顆粒細胞瘤。(1)顆粒細胞成分:
主要為成人型顆粒細胞瘤,鮮為幼年型顆粒細胞瘤。
(2)好發年齡
成人型細胞瘤:大部分發生於絕經後婦女,30%左右發生於育齡婦女。幼年型細胞瘤:絕大多數發生在30歲以前。約44%發生在出生後至10歲以下,34%發生在10~19歲,19%發生在20~29歲。
併發症
過大腫瘤可出現蒂扭轉。症狀:突然下腹部劇烈疼痛,偶因子宮內膜血管充血而致有少量子宮出血。可伴有噁心、嘔吐,甚至休克。鑑別診斷
1、顆粒細胞-間質細胞瘤(granulosastromalcelltumor):由性索的顆粒細胞及間質的衍生成分如成纖維細胞及卵泡膜細胞組成。(1)顆粒細胞瘤(granulosacelltumor):
為低度惡性腫瘤,多為單側,大小不一,圓形或橢圓形,呈分葉狀,表面光滑,實性或部分囊性,切面組織脆而軟,伴出血壞死灶。
鏡下:顆粒細胞環繞成小圓形囊腔,菊花樣排列,即Call-Exner小體。囊內有嗜伊紅液體。瘤細胞呈小多邊形,偶呈圓形或圓柱形,胞漿嗜淡伊紅或中性,細胞膜界限不清,核圓,核膜清楚。能分泌雌激素,有女性化作用:
A.青春期前患者可出現假性性早熟,生育年齡患者出現月經紊亂,絕經期後患者有不規則陰道流血
B.合併子宮內膜增生症,甚至發生腺癌。
(2)卵泡膜細胞瘤(thecacelltumor):為良性腫瘤,多為單側,大小不一。圓形、卵圓形或分葉狀。表面被覆有光澤、薄的纖維包膜。切面實性,灰白色。
鏡下:見瘤細胞短梭形,胞漿富含脂質,細胞交錯排列呈漩渦狀。瘤細胞團為結締組織分隔,能分泌雌激素,有女性化作用。常合併子宮內膜增生症,甚至子宮內膜癌。
(3)纖維瘤(fibroma):多見於中年婦女,單側居多,表面光滑或結節狀,切面灰白色,實性、堅硬。鏡下:由膠原纖維的梭形瘤細胞組成,排列呈編織狀。偶見梅格斯綜合徵(Meigssyndrome):伴有腹水或胸腔積液,多見右側胸腔積液。切除腫瘤後,胸腔積液腹水自行消失。
2、支持細胞-間質細胞瘤(sertoli-leydigcelltumor):又稱睪丸母細胞瘤(androblastoma) 多發生在40歲以下婦女,單側居多,腫瘤較小,可局限在卵巢門區或皮質區,實性,表面光滑而濕潤,有時呈分葉狀,切面灰白色伴囊性變,囊內壁光滑,含血性漿液或粘性液體。鏡下:由不同分化程度的支持細胞及間質細胞組成。多為良性,主要分泌雄激素,具有男性化作用。
3、卵巢環管狀性索腫瘤:分泌雌激素、雄激素。並發Pentz-Jeghers綜合症,病理檢查的上皮巢內有環狀小管。
發病機制
1.大體檢查大多為單側,直徑6~20cm,大多在6cm以下。卵圓形,有或無包膜,表面光滑。切面灰黃、灰粉或棕色,多為實性,亦可有多房或囊性。
2.顯微鏡下檢查腫瘤含有支持細胞、間質細胞以及結構清楚的含Call-Exner小體的顆粒細胞、泡膜細胞。這些性索間質成分在腫瘤中相互混雜,而不是相互獨立的成分。
輔助檢查
1、激素水平檢查:雌激素、睪酮水平增高者。2、組織病理學檢查。
(1)大體檢查多為單側,平均直徑6cm以下。卵圓形,表面光滑。切面灰黃、灰粉或棕色。多為實性,亦可有多房或囊性。
(2)顯微鏡下檢查
含有支持細胞、間質細胞以及結構清楚的含Call-Exner小體的顆粒細胞、泡膜細胞,並在腫瘤中相互混雜。
3、腫瘤標記物抑制素及MIC2免疫組織化學染色陽性:存在成人型顆粒細胞瘤。
4、腹腔鏡檢查
疾病預防
一、預防:1、定期檢查,注意早期發現、治療。
2、術後嚴密隨訪。
二、術前準備:
1、糾正術前各種併發症。
2、.陰道及腸道準備:陰道擦洗3天。術前半流質2天,流質1天,術前3天口服滅滴靈。
3、腫瘤標記物檢查:CA125、CEA、AFP、HCG等。
4、肝、膽、脾等進行超音波或CT檢查,了解有無占位性病變。
5、進行靜脈腎盂造影等泌尿系統檢查。
6、鋇餐、鋇劑灌腸等全面的胃腸檢查,觀察是否有卵巢轉移瘤。
7、一般性術前檢查。如血尿常規、出凝血時間、血小板,心、肝、肺、腎等臟器功能的檢查。
8、充分配血。
飲食保健
一、食療方1、參芪健脾湯:當歸10g,高麗參10g,桂圓肉14g,黃芪10g,枸杞子15g,陳皮5g,黨參18g,山藥18g,豬排骨300g或整光雞1隻,清水適量。製法:高麗參,黃芪等中藥洗淨後放入布袋中扎口,和排骨或雞一起加水煮。先大火後小火,煮2-3小時,撈出布袋,加入鹽、胡椒等調味品即可。用法:每次1小碗,每天1次.以上物料可做出5小碗。吃肉喝湯,多餘的放入冰櫃保存。功效:健脾益肺,開胃壯神。適應症:卵巢癌手術後的調理。
2、陳香牛肉:陳皮30g,香附子15g,牛肉500g,蔥、姜、鹽適量。製法:將陳皮與香附子加水2000g煎半小時去渣,放入牛肉加蔥、姜、鹽等調料,文火燉至酥爛,涼透切片食之。功效:舒肝理氣,健脾益氣。
3、商陸粥配方:粳米100g,商陸10g,大棗5枚,清水適量。製法:先將商陸用水煎汁,去渣,然後加入粳米,大棗煮粥,空腹食之,微利為度,不可過量。功效:健通利二,利水消腫。適應症:卵巢癌排尿困難所致腹水。
二、飲食保健
1、主食應以饅頭、麵包、包子、餃子等麵食為主等。
2、只能食用少量瘦、嫩筋少的豬肉、牛肉、雞胸脯、魚肉、蝦肉、肝泥,並且一定要剁碎煮飲,或先燉爛再切碎。
3、蛋類不油炸。
4、水果應去皮,不食花生、杏仁、核桃等乾堅果類。
5、多吃具有抗腫瘤作用的食物:鱟、海馬、龍珠茶、山楂。
6、出血:宜吃羊血、螺獅、烏賊、淡菜、薺菜、藕、馬蘭頭、蘑菇、石耳、榧子、柿餅。
7、感染:宜吃鰻魚、文蛤、針魚、鯉魚、麒麟菜、芹菜、水蛇、芝麻、蕎麥、香椿、油菜、赤豆、綠豆。
8、腹痛、腹脹:宜吃豬腰、楊梅、山楂、橘餅、核桃、栗子。
9、不吃蔥、蒜、椒、桂皮等刺激性食物。
10、不吃肥膩、油煎、霉變、醃製食物。
11、不吃羊肉、狗肉、韭菜、胡椒等溫熱食物。
醫學疾病任務——婦科
| 婦科是醫療機構的一個診療科目,是婦產科的一個分支專業,是以診療女性婦科病為診療的專業科室。女性生殖系統所患的疾病才叫婦科疾病。婦科疾病的種類可分很多種,本任務包含大多數婦科疾病。 |
